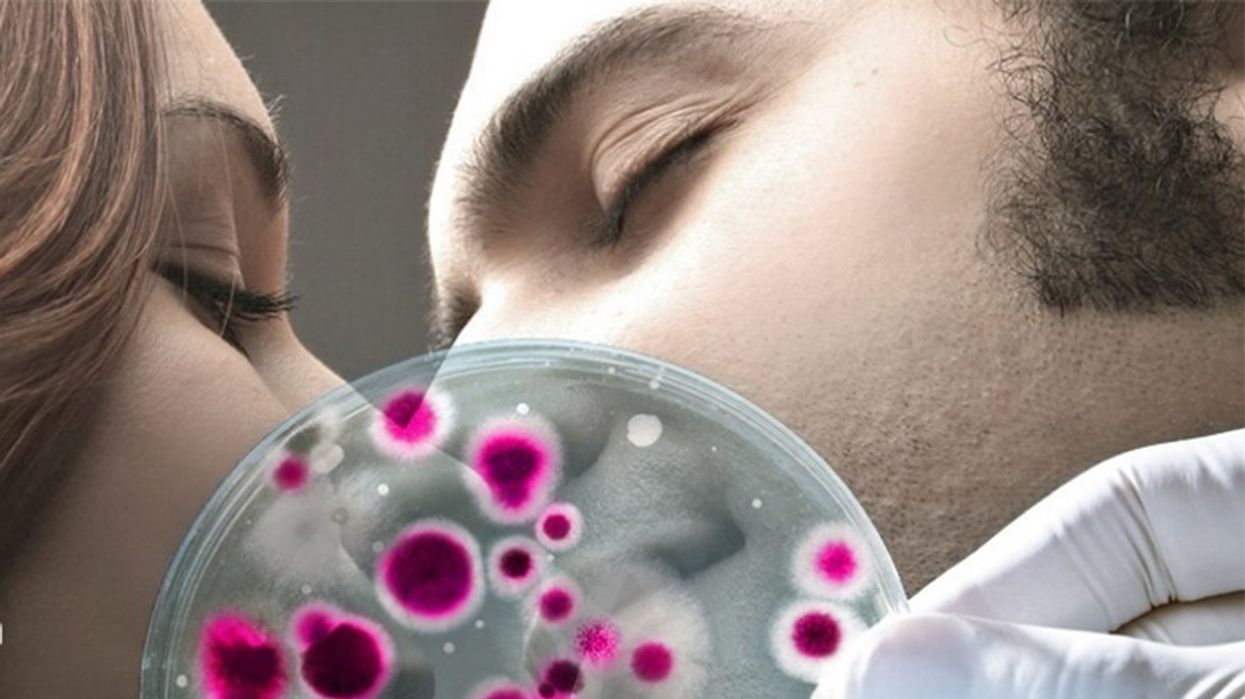
2017/12/9-74.jpg

Përmes puthjes barten 80 milionë baktere
Në ekosistemin njerëzor jetojnë 100 bilionë mikroorganizma, jashtë dhe brenda trupit. Njerëzit nuk janë të vetëdijshëm për ta, por këta organizma u ndihmojnë në tretje dhe në mbrojtje kundër sëmundjeve. Pa ta, vështirë se do të mbijetonin.
Goja është vatër e rreth 700 llojeve të ndryshme të baktereve, ndërsa hulumtuesit holandezë nga një organizatë e atjeshme për aplikimin e kërkimeve shkencore (TNO) kanë vendosur që të hulumtojnë se çfarë ndodh me ta gjatë puthjes. Rezultatet u botuan në revistën “Microbiome”.
Ata punuan me 21 çifte, të cilat së pari duhej ta plotësonin një pyetësor për atë se sa shpesh puthen në ditë dhe sa kohë u zgjat puthja. Pastaj morën mostra nga gojët dhe gjuha e tyre, në mënyrë që të përcaktojnë se çfarë lloj mikrobesh jetojnë në to.
Ata konstatuan se çiftet që putheshin mjaft shpesh dhe mjaft gjatë, që nënkupton një mesatare prej nëntë herë në ditë, në fund e kanë një komunitet shumë të ngjashëm të mikrobeve në gojë.
Hulumtuesit gjithashtu llogaritën se sa e ndryshojnë mikrobet “habitatin” e tyre gjatë puthjes franceze. Një anëtar i çiftit më parë kishte pirë pije probiotike, e cila përmban baktere të cilat identifikohen lehtë. Ata konstatuan se gjatë puthjes dhjetë-sekondëshe transferohen 80 milionë baktere.
Për ata që duan të dinë më shumë, bakteret nga pështyma më lehtë “udhëtojnë”, ndërsa ato që ndodhen në gjuhë duket të jenë më të qëndrueshme.
Edhe pse një numër prej 80 milionë bakteresh tingëllon frikshëm, kjo është në fakt një gjë e mirë, sepse bëhet fjalë për një lloj “vaksine” dhe strukture të rezistencës imunitare ndaj ekspozimit të mikroorganizmave të ndryshëm.
“Nga ky këndvështrim, puthja është shumë e shëndetshme”, tha profesori holandez Remco Kort. /Telegrafi/





















































